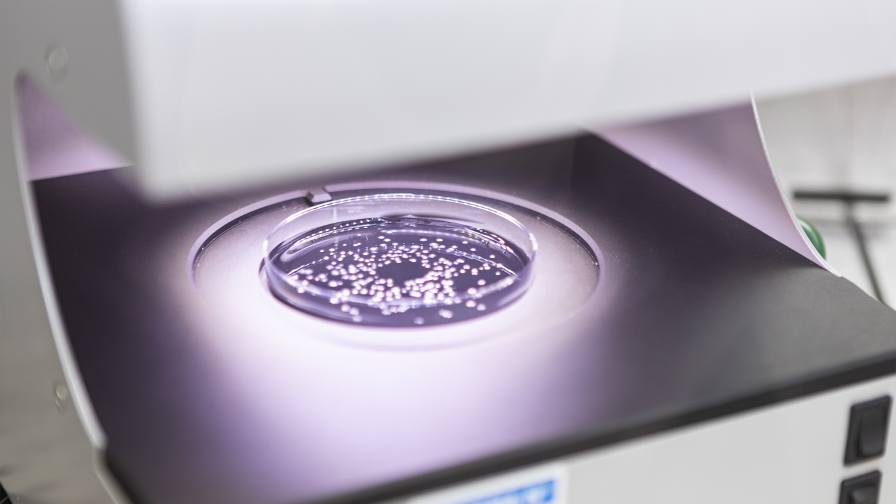

New NHS IP Guidance Aims to Unlock Billions for the UK's Economy
The UK government has launched a comprehensive overhaul of its rules surrounding National Health Service (NHS) inventions, aiming to unlock billions for the economy by expediting the development and commercialisation of homegrown medical innovations. This …